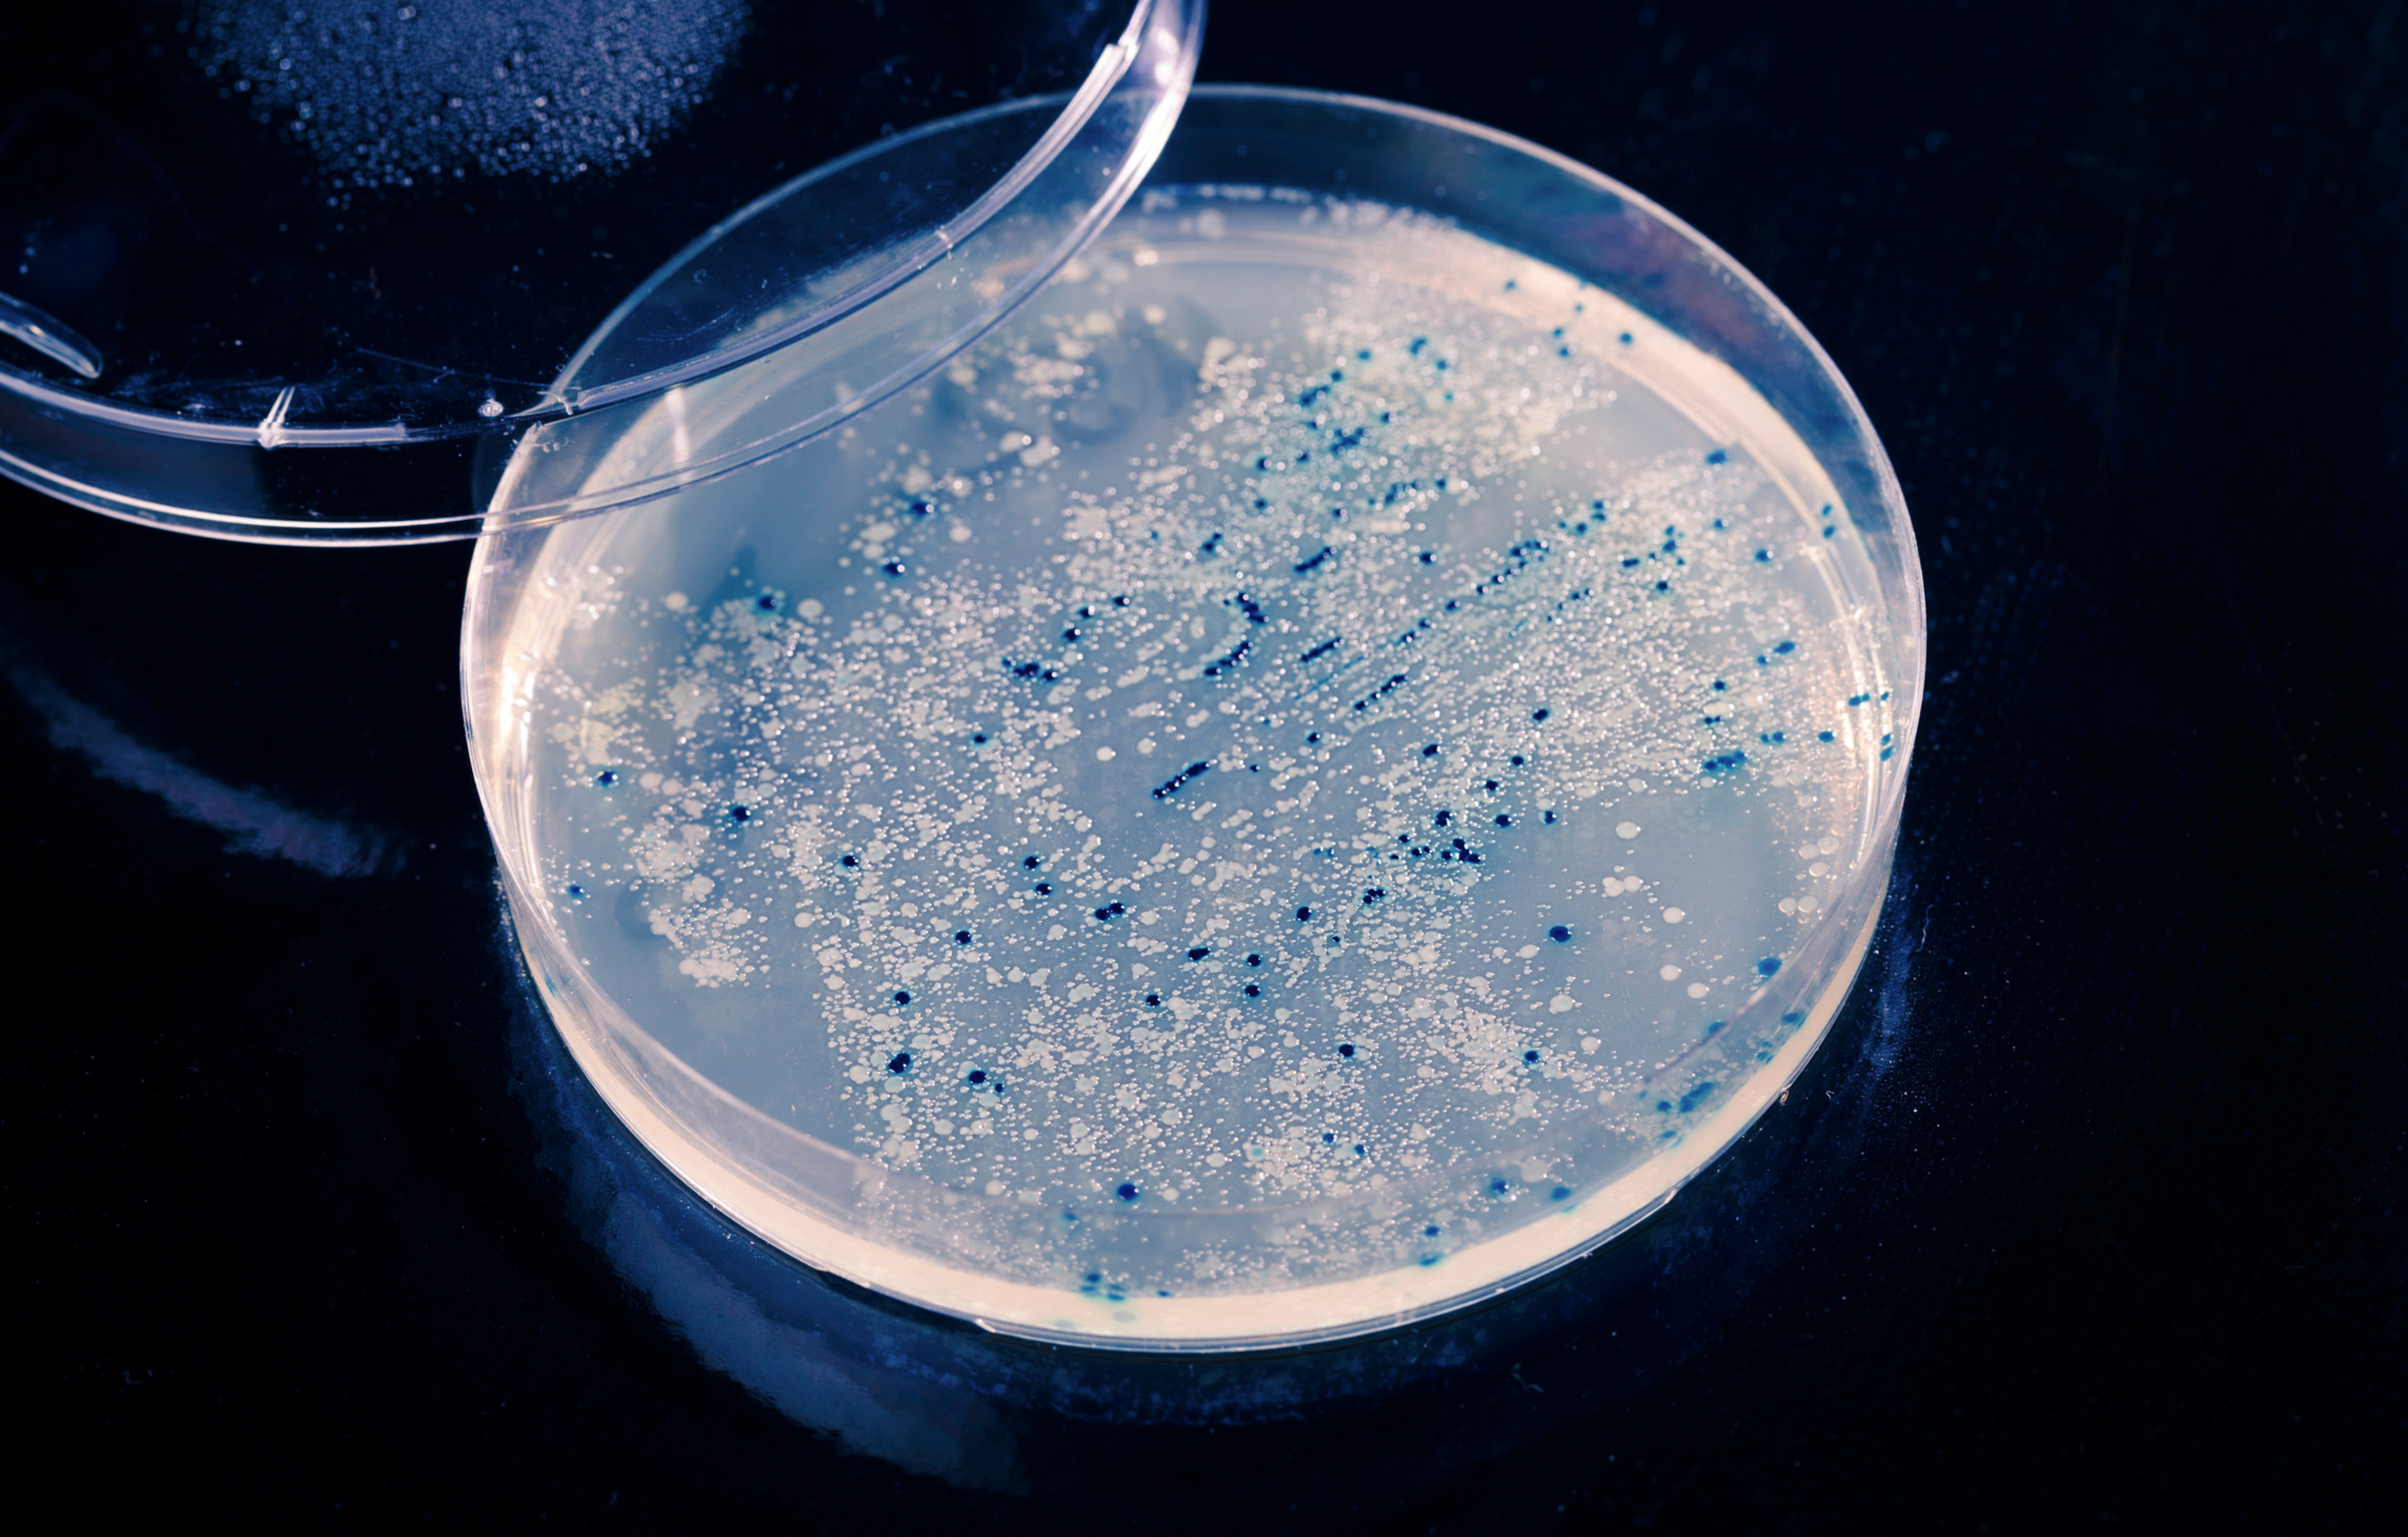
Listeria Monocytogenes
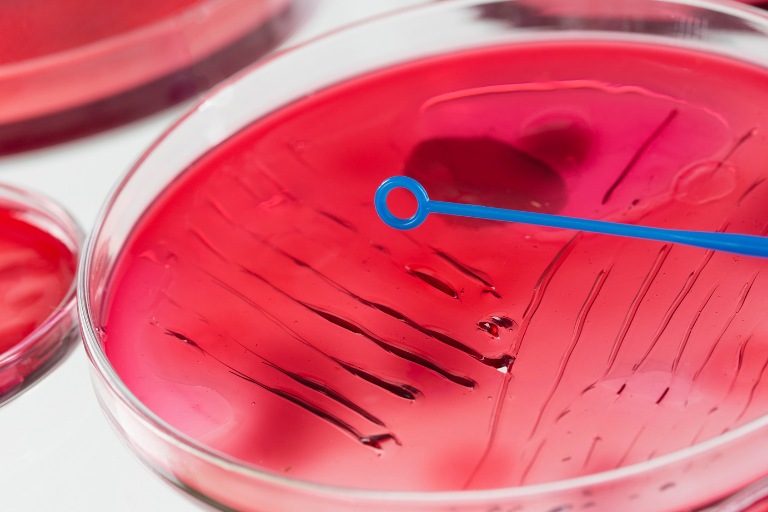
Challenge Tests et nouveau référentiel

Nos Webinaires

Tous les mois, le réseau Eurofins vous propose d'assister à un webinaire réalisé par l'un de ses spécialistes. En 30 minutes, ces visioconférences à distance sont l'occasion d'échanger sur des évolutions réglementaires, sur des solutions analytiques et techniques adaptées ou nouvelles dont l'objectif est de vous accompagner à rendre la qualité des aliments toujours plus sûre, saine, authentique et responsable.
Vous trouverez ici les webinaires à venir et ceux disponibles en replay. Pour toute question, contactez EventsFr@eurofins.com
Nouveauté

Webinaire du 05/03/2026 - "Fruits et légumes : comment s'appuyer sur une expertise locale pour répondre aux nouvelles exigences ou alertes ?"
Intervenants :
Guilain de PLINVAL, Directeur du laboratoire régional Eurofins Analyses Pesticides Alimentaires Ouest (à Nantes) et Jérôme GINET, Directeur des laboratoires Eurofins Analyses Contaminants
Durée : 30 min
📢 Pour toujours mieux accompagner l'ensemble des acteurs de la filière végétale et maraîchère du grand Ouest (producteurs, coopératives, transformateurs, grossistes), nous avons créé un laboratoire 100% dédié au contrôle de la qualité de vos fruits et légumes : Eurofins Analyses Pesticides Alimentaires Ouest.
📌Au cours de ce webinar gratuit, Guilain de PLINVAL, directeur de ce laboratoire, et Jérôme GINET évoqueront les dernières actualités et les solutions analytiques associées concernant la qualité de vos productions végétales :
- Arrêté français du 5 janvier 2026 applicable au 8 février : interdiction d'importation de F&L contenant des résidus de pesticides interdits en UE, molécules concernées et denrées impliquées
et quel plan de contrôle efficace mettre en place pour maîtriser les non-conformités ? - Polluants éternels PFAS (perfluoroalkylées et polyfluoroalkylés): rappel réglementaire UE et recommandations EFSA, émergence du risque PFAS ultracourts (TFA), niveaux d’alertes
- Notre accompagnement local, complet et accrédité* : dédié 100% à l’analyses des fruits & légumes, proximité et rapidité : mise en analyse le jour même, collecte de vos échantillons dans toute la région Grand Ouest, interlocuteur dédié.
/!\ Nombre de places limité /!\
→ Pour vous inscrire, contactez vite eventsFr@eurofins.com
* Voir portée d’accréditation 1-0287 disponible sur www.cofrac.fr
Précédents Webinaires
Année 2026
Année 2025
Année 2022
Année 2021
Année 2020